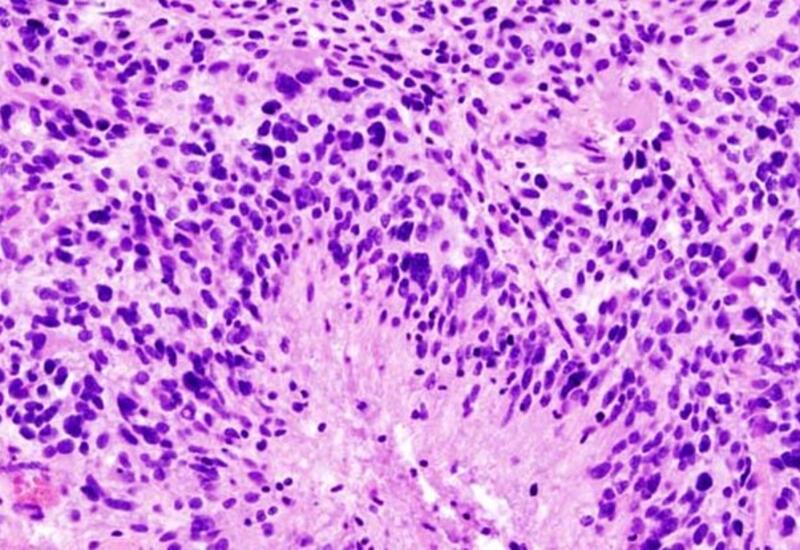

Раскрыта особая опасность рака мозга
Ученые из Медицинского колледжа Альберта Эйнштейна показали, что глиобластома - самый агрессивный вид рака мозга - поражает не только мозг, но и кости черепа. Исследование, опубликованное в Nature Neuroscience (NN), выявило: опухоль разрушает черепные швы, изменяет состав костного мозга и нарушает работу иммунной системы, передает Day.Az со ссылкой на Lenta.ru.
Эксперименты на мышах и анализ снимков пациентов показали, что глиобластома вызывает истончение костей и расширение каналов между черепом и мозгом. По этим каналам к опухоли устремляются воспалительные клетки из костного мозга, делая ее более агрессивной и устойчивой к лечению.
Ученые зафиксировали серьезный дисбаланс иммунных клеток: увеличивается число воспалительных нейтрофилов, а защитные B-клетки почти исчезают. Это может объяснять, почему традиционные методы терапии, ориентированные только на мозг, оказываются малоэффективны.
Попытки остановить разрушение костей с помощью препаратов от остеопороза привели к неожиданному эффекту - в одном из случаев опухоль росла быстрее, а иммунная терапия теряла эффективность. Авторы подчеркивают: глиобластому нужно рассматривать как системное заболевание, а новые подходы к ее лечению должны учитывать изменения в костях и иммунной системе.
Заметили ошибку в тексте? Выберите текст и сообщите нам, нажав Ctrl + Enter на клавиатуре



